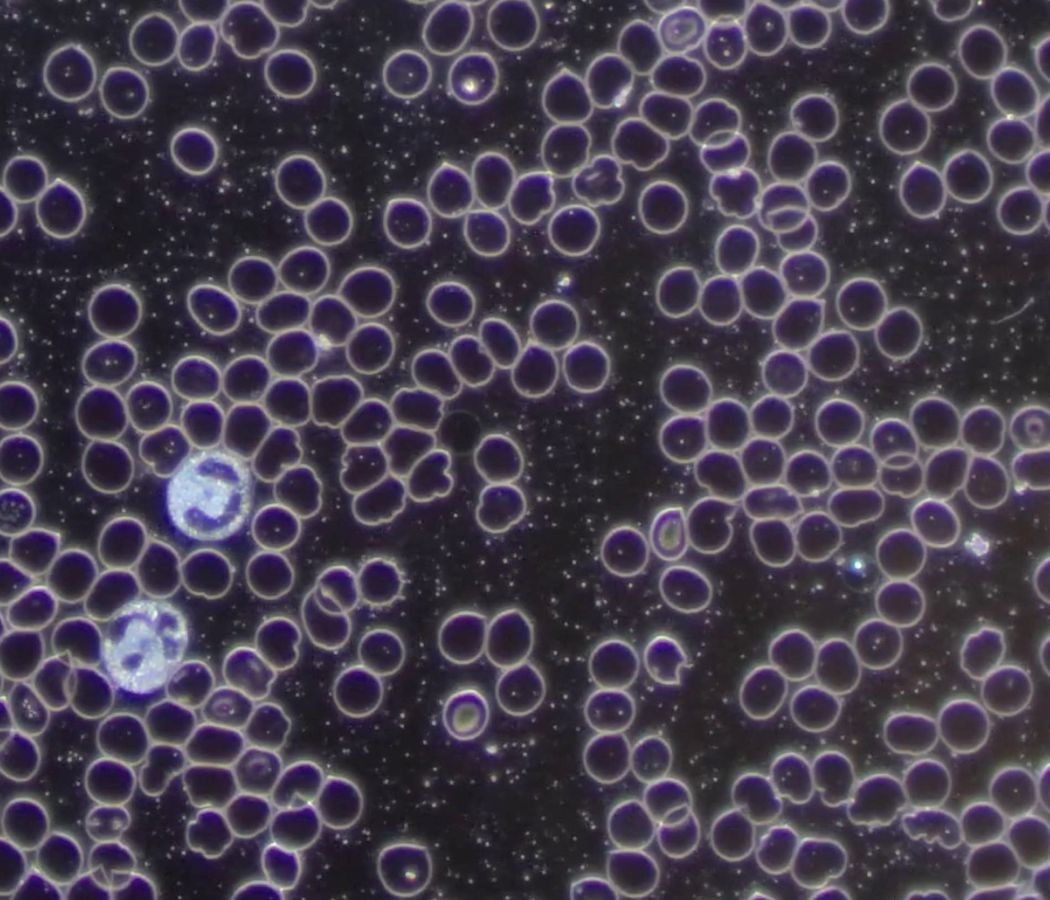
Blut unterm Dunkelfeldmikroskop

Testen und messen statt raten
bei deiner Gesundheit
Ermittlung deiner Gesundheitswerte
Bestimmung vor Ort:
Basic: Messung von Glucose, Cholesterin, Triglyceride, Blutdruck, Puls, Temperatur, Gewicht und Größe
Plus: DNA Tests, Haaranalyse, Omega-3-Index, Verhältnis von Omega 6 zu Omega 3, Fettsäurestatus, Vitamin D + Vitamin K Messung und laufend weitere …
Online Angebote:
Angeleitete Selbsttests: DNA Tests, Haaranalyse, Omega-3-Index, Verhältnis von Omega 6 : Omega 3, Fettsäurestatus, Vitamin D + Vitamin K Messung und laufend weitere…
Gerne arbeite ich in beiden Fällen auch mit bereits vorhandenen Befunden und Werten.
Ablauf
Anamnese: Besprechung deines Anliegens
Wir besprechen deine Situation ausführlich und finden heraus, was dir gut tut.
Mit deiner persönlichen Ausgangslage ziehe ich Rückschlüsse auf mögliche Mängel.
Durch die verschiedenen gewünschten Tests, werden sie sichtbar und kontrollierbar.
Dein Gesundheitsplan – individuell auf deinen Körper und deine Lebensweise abgestimmt
Ich arbeite für dich einen Plan aus, wie du deine Gesundheit mit einer optimalen Versorgung, durch Ausgleich mangelnder Mikronährstoffe, stärkst.
Ergänzend besprechen wir, wie du deine Gesundheit und dein Wohlbefinden mit einem förderlichen Lifestyle sowie positivem Mindset unterstützen kannst. Hierbei ist mir sehr wichtig, dass es für dich leicht umsetzbar ist.
Nachbesprechung
In einer ausführlichen Besprechung ziehen wir nach drei Monaten Bilanz,
inwiefern sich deine Lebensqualität durch deinen Gesundheitsplan und die damit gesetzten Tätigkeiten verbessert hat.
Bei einem bestehenden Krankheitsbild erfolgt die Nachbesprechung nach sechs Monaten.
Alternative Methoden:
Dunkelfeldmikroskopie
Mit der Beurteilung des lebenden Blutes können Aussehen, Aktivität und Funktionstüchtigkeit der Blutkörperchen ermittelt und Rückschlüsse gezogen werden. Im so genannten Dunkelfeld werden die Blutzellen in bis zu 1000-facher Vergrößerung beobachtet. Wie lang das Blut außerhalb des Körpers überlebt sagt auch viel über die Selbstheilungskräfte der Person aus.
Kinesiologie: Touch for health
Durch die Methode des Muskeltests können Nahrungsmittel und Mikronährstoffe ausgetestet werden. Im Touch for health - Gesund durch Berühren, sind Elemente aus der Chiropraktik, Akupressur, der Ernährungswissenschaft sowie Bewegungslehre enthalten. Die Behandlung zielt darauf ab, Blockaden im Energiesystem ausfindig zu machen und aufzulösen.
Als deine Vitalschwester stehe ich dir mit meinem medizinischen und alternativmedizinischen Wissens- und Erfahrungsschatz zur Seite.
Ich unterliege der Verschwiegenheitspflicht und ersetze keine(n) Arzt / Ärztin.
Extra:
Buche mich für einen Fachvortrag
- Möchtest du mehr zum Thema Mikronährstoffe und gesunder Lebensweise erfahren?
- Ist es dir wichtig, deinen Betrieb und deine Mitarbeiter:innen für Gesundheitsthemen zu sensibilisieren?
- In einem individuell zugeschnittenen Fachvortrag teile ich gerne mein Wissen.
Zum Beispiel: Gesund durchs ganze Jahr / Mit Konzentration und Fokus durch den Tag
Meine Kunden: Hotels, Firmen und Fachleute aus dem Gesundheitswesen
Buche mich für eine interaktive Schulstunde
Da mir als Mama Kinder besonders am Herzen liegen, biete ich ehrenamtlich an, eine Einheit zum Thema ganzheitliche Gesundheit und positives Mindset zu übernehmen.